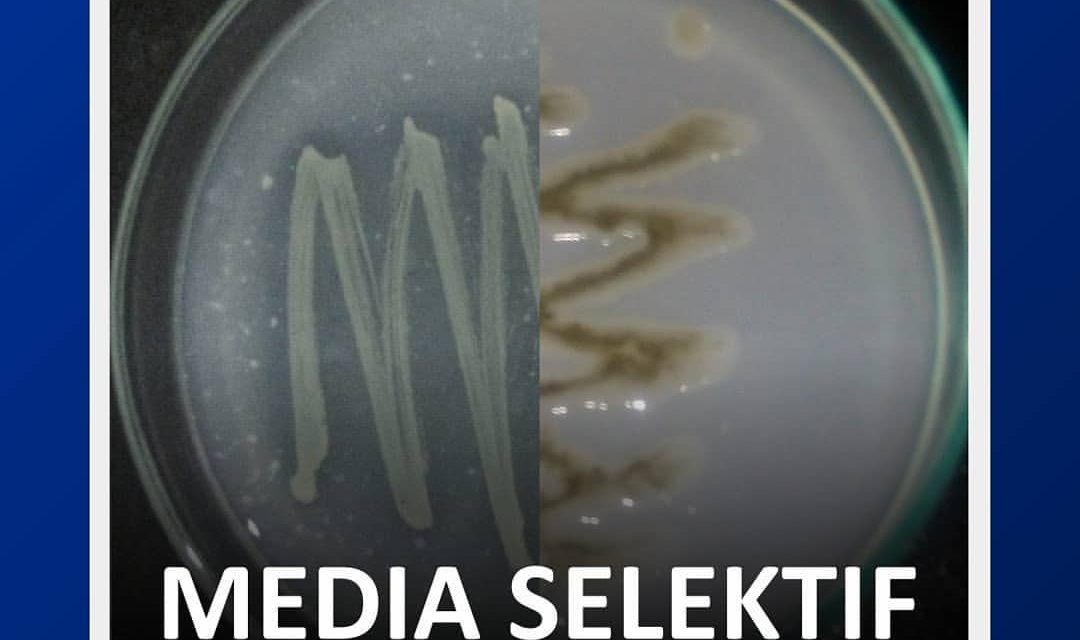

Terdapat berbagai aktivitas dalam proses pelaksanaan analisis sampel di Laboratorium, salah satunya pemanasan pada proses destruksi basah. Ingin tau perangkat apayang digunakan…

Muffle furnace atau yang dikenal sebagai tanur adalah tungku suatu bahan diisolasi dalam ruang dengan suhu tinggi pada waktu tertentu.

Bila dipostingan sebelumnya kita membahas tentang persiapan fisik sampel pada proses persiapan sampel jaringan tanaman, maka kali ini kita akan membahas tentang…

Analisa jaringan tanaman kelapa sawit penting untuk dilakukan guna mengetahui kadar ketersediaan hara pada tanaman, sehingga dapat disusun rekomendasi pemupukan yang tepat…

Haemocytometer adalah sebuah alat yang digunakan untuk menghitung jumlah sel ataupun partikel mikroskopis seperti spora jamur, sel bakteri, dan lainnya.

Tahukah kamu bakteri dapat diwarnai? Untuk apa ya tujuan dari pewarnaan bakteri? Cari informasi lengkapnya pada infografis yang telah kami buat!

Isolasi merupakan teknik pengambilan mikroorganisme yang terdapat di alam dan ditumbuhkan ke dalam suatu medium buatan.

Bagaimana cara mengetahui kadar nitrogen pada daun? terdapat 2 cara untuk mengetahui kadar nitrogen yang terdapat pada daun, yaitu menghitung kadar nitrogen…

Proses penentuan kualitas Tandan Buah Segar di Laboratorium ditentukan berdasarkan banyaknya kandungan minyak dalam satu buah tandan atau Oil per Bunch dengan…
Media selektif merupakan media agar yang digunakan untuk mengisolasi atau mengidentifikasi organisme tertentu.




